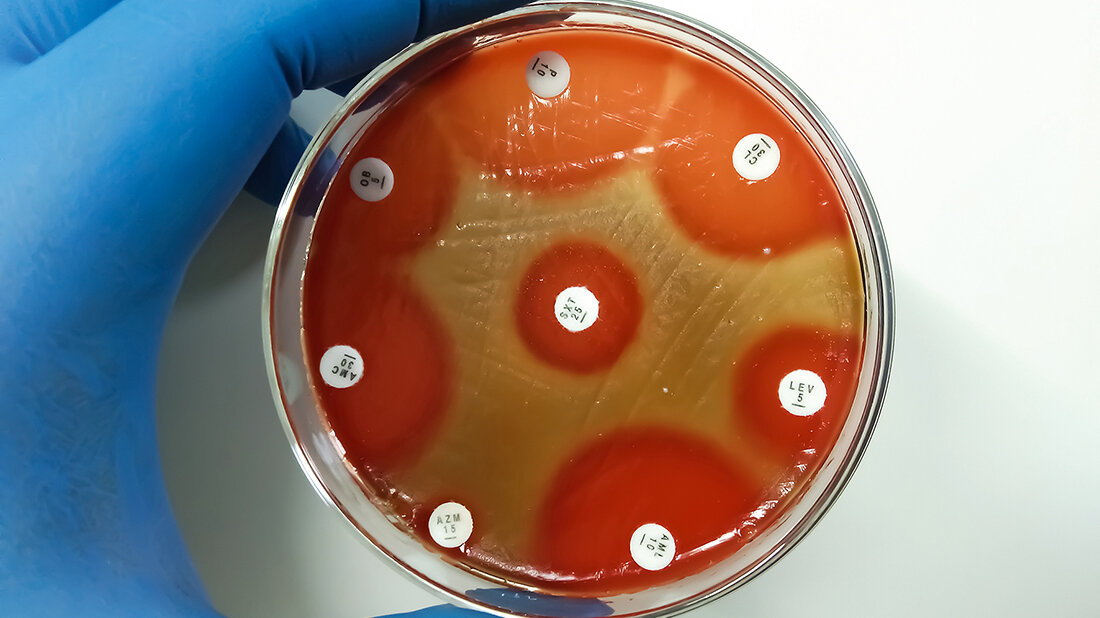
Titelbild des Fachbeitrags zum Risiko durch Scharlachausbrüche

Tödliche Scharlachausbrüche in Großbritannien
Zusammenfassung
Die Weltgesundheitsorganisation (WHO) hat am 10. Dezember 2022 über einen Anstieg von schweren, teils tödlich verlaufenden Erkrankungen durch A-Streptokokken-Infektionen in mindestens 5 Ländern in Europa berichtet (Frankreich, Irland, Niederlande, Schweden, Vereinigtes Königreich). In jüngster Zeit wurden vereinzelt epidemische Ausbrüche vorwiegend bei Kindern bereits beschrieben. Scharlach wird durch A-Streptokokken verursacht. Er ist durch einen Hautausschlag bei Kindern gekennzeichnet, kontagiös, kann endemisch, epidemisch oder sporadisch auftreten. Die Krankheit tritt meist im Winter und Frühjahr auf. Scharlach kann zu Komplikationen und Post-Streptokokken-Erkrankungen wie zum Beispiel rheumatischem Fieber, Myokarditis oder akuter Glomerulonephritis führen. Die Infektion ist gut mit Antibiotika zu therapieren. Die Mehrzahl derjenigen, die an Scharlach erkranken, sind Kinder unter 10 Jahren. Der Beitrag ordnet das aktuelle Ausbruchsgeschehen ein.
Schlüsselwörter: A-Streptokokken Infektion (GAS), Scharlach, Ausbruchsgeschehen, Ursachen, Historik, Therapie, Prävention
Abstract
On December 10, 2022, the World Health Organization (WHO) reported an increase in serious, sometimes fatal, diseases caused by A streptococci infections in at least 5 countries in Europe (France, Ireland, the Netherlands, Sweden, the United Kingdom). Recently, isolated epidemic outbreaks predominantly in children have been described. Scarlet fever is caused by group A streptococci. It is characterized by a rash in children, is contagious, can be endemic, epidemic or sporadic. The disease occurs mostly in winter and spring. Scarlet fever can lead to complications and post-streptococcal diseases such as rheumatic fever, myocarditis or acute glomerulonephritis. The infection can be treated well with antibiotics. The majority of those who develop scarlet fever are children under the age of ten. The article classifies the current outbreak events.
Keywords: A Streptococci Infection (GAS), scarlet fever, outbreak-events, causes, history, therapy, prevention
DOI: 10.53180/MTIMDIALOG.2023.0118
Entnommen aus MT im Dialog 2/2023
Dann nutzen Sie jetzt unser Probe-Abonnement mit 3 Ausgaben zum Kennenlernpreis von € 19,90.
Jetzt Abonnent werden